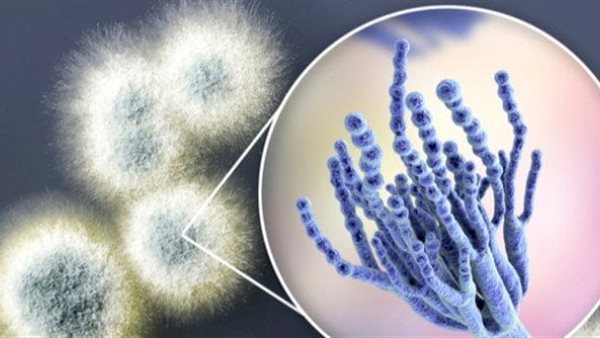
الفطريات

الفطريات تسبب الإصابة بسرطان القولون والمستقيم| دراسة
أظهرت دراسة جديدة، أن الفطريات تسببت في الإصابة بسرطان القولون والمستقيم، بين البالغين الأصغر سنًا، وفقًا لصحيفة ديلي ميل البريطانية.
ارتفاع كبير في إصابات سرطان القولون
وأثار الارتفاع الغامض في الحالات بين الذين تقل أعمارهم عن 55 عامًا، مخاوف في الأوساط الطبية، خاصة أن السرطان يتم اكتشافه بين الشباب الأصحاء الذين يركضون الماراثون، ويراقبون نظامهم الغذائي.
وقال الأطباء في جامعة جورج تاون بواشنطن العاصمة، إن الزيادة الطفيفة يمكن ربطها بالتغيرات في ميكروبات أمعاء الشباب.
ووجدوا أن الأورام المأخوذة من المرضى الأصغر سنًا، كانت أكثر عرضة لاحتواء فطر Cladosporium sp، عند مقارنتها بالمرضى الأكبر سنًا.
الفطريات السبب في الإصابة
وتوجد الفطريات في بعض الأحيان فقط في الأمعاء البشرية، حيث يُشتبه في أنها غازية لا تساعد في الهضم، ومن المعروف أيضًا أن الفطريات، تسبب التهابات في الجلد والأظافر.
ويعد سرطان القولون والمستقيم، ثالث أكثر أنواع السرطانات شيوعًا التي يتم تشخيصها في الولايات المتحدة، وفقًا للمعهد الوطني للسرطان.
ويتم تشخيص حوالي 153000 أمريكي بسرطان القولون والمستقيم كل عام، منهم 19550 تحت سن الخمسين، وتضاعفت المعدلات في سن 55 عامًا منذ تسعينيات القرن الماضي، مما يثير القلق بين المهنيين الصحيين.
وأظهر تقرير عام 2023، لجمعية السرطان الأمريكية على أن معدل الإصابة بسرطان القولون والمستقيم لدى الأمريكيين، الذين تقل أعمارهم عن 55 عامًا ارتفع من 11 %، من جميع الحالات في عام 1995 إلى 20 بالمائة في عام 2019.
وقال الدكتور بنجامين واينبرج، خبير سرطان الجهاز الهضمي، في إفادة صحفية: يلقي الكثير من الناس باللوم على السمنة ومرض السكري.
وأضاف: لكن لدينا هؤلاء المرضى الذين يجرون سباقات الماراثون، ويأكلون وجبات صحية، ولديهم سرطان القولون والمستقيم المتقدم للغاية.
وقاموا بفحص الحمض النووي للكائنات الحية الدقيقة في الأورام، للبحث عن أي اختلافات في ميكروبيوم الأمعاء.
وسيتم تقديم النتائج الأسبوع المقبل، في الاجتماع السنوي للجمعية الأمريكية لعلم الأورام السريري في شيكاغو.
وقال الباحثون، إن ورقتهم البحثية، ربما تكون قد قربت الأطباء خطوة واحدة، من فهم سبب ارتفاع حالات سرطان القولون والمستقيم.




















